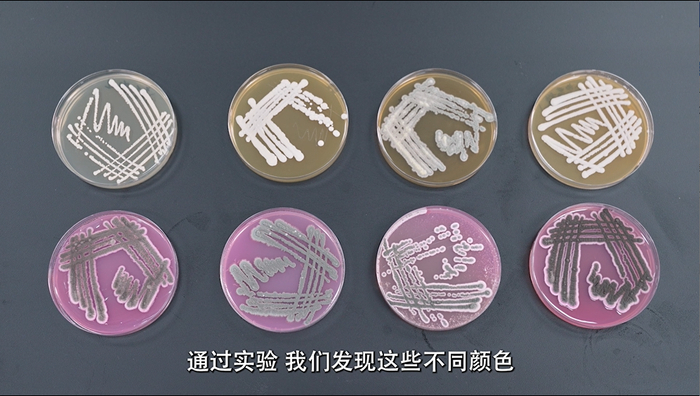

来源:人民网科普
炎炎夏季,有消费者反映,在酱油瓶口、瓶壁突然出现一层“白膜”,甚至酱油表面飘着一些白色漂浮物……
这些令人不悦的“不明物质”到底是什么?是传闻猜测的霉斑吗?如果确实是长霉,现在又湿又热的天气,我们怎样才可以避免家里的调味品长霉?
带着这一系列的疑问,我们邀请到了江苏大学食品与生物工程学院高献礼教授,让我们一起通过几个小实验,揭开酱油长霉的真实原因,也教大家几招最管用的,科学保存调味品的小技巧!
问
酱油瓶内出现的不明物质是什么?
主要是霉菌。
可能很多人通过观察已经猜到,这些类似霉斑的“不明物质”,主要就是霉菌。
我们通过实验进一步检测,证实这些外形呈绒毛状的白色、灰色、黄色、褐色、绿色的“不明物质”,确实就是霉菌和酱油长时间接触,大量生长繁殖形成的霉斑。
这里要特别提醒的是,有些人可能会把酱油表面那层白膜倒掉,剩下的酱油接着用,我们不建议这样。跟食物长霉类似,一旦发现酱油长霉,就千万不要再食用了,超过保质期或者长霉的调味品不宜再食用。
问
为什么新买的酱油刚用几天就长霉?
大概率是开封后保存不当,接触到空气中的霉菌。
为什么新买的酱油刚用几天就长霉?遇到这个问题先别着急,其实酱油长霉和我们日常生活中的面包、水果等食品长霉的原理相似:

当食物打开包装,长时间暴露在空气中,霉菌就会“溜”到食物表面,“乘机”利用食物中丰富的营养物质迅速生长和繁殖,引起食物长霉变质、产生异味等。
酱油中也含有丰富的营养物质,也是霉菌的“最爱食物”。霉菌虽然小到肉眼都看不见,但实际上它们就广泛存在于空气里,一有机会,这个“贪吃鬼”就会偷袭!

通过验证,我们判定酱油长霉是因为没有拧紧瓶盖或瓶口有残留,长时间与空气接触,感染霉菌长霉了。所以,我们每次用完酱油,一定要记住擦干净瓶口,马上盖好瓶盖,隔绝酱油与空气接触。
问
高温高湿的梅雨季节,酱油更容易长霉吗?
是的。
说起霉菌,我们听说它还特别喜欢潮湿而且温暖的梅雨季节!
为了证实这点,我们特地使用4个培养箱,分别模拟一年四季不同温度、湿度特点,研究霉菌的变化。
实验证明,大多数霉菌在温度大于25℃,相对湿度高于85%时,生长较快,而这样的温度、湿度恰好是梅雨季节的典型表现。

此外,我们还了解到,潮湿的空气也会导致酱油稀释,使其更容易受环境中的霉菌污染。
所以说,每年高温高湿的梅雨季节,我们更要着重整顿好厨房卫生,保持干净、干燥、整洁,做好和霉菌对抗的十全准备。如果酱油瓶口碰到水,要及时擦干。
问
酱油出厂前自带霉菌?
不可能。
有消费者曾经表示担忧“我买回家的酱油,会不会在出厂前就自带了霉菌?”根据消费者的反馈,我们做了相关调查,发现正规厂家生产时一般采用高温灭菌(成品酱油会进行超过90℃的高温灭菌),而霉菌超级“怕热”,在超过50℃的环境中会快速死亡。所以,经过高温灭菌后,想在酱油里找到霉菌的身影,那可太难了。
除此之外,霉菌跟我们人一样,需要“呼吸空气”才能存活,酱油灌装封口后会隔绝空气,霉菌也就没有了感染的途径。所以,只要是从正规厂家生产出来的酱油,出厂前霉菌可以说是毫无生存机会的。
这里也给大家总结一条公式:
高温灭菌 + 密封隔绝空气 = 霉菌无法存活!
除了理论研究,也为了更实在地验证这个说法,我们决定做一个实验:
我们从市面上选择了较畅销的9款酱油,每款2瓶(1瓶开封、1瓶不开封),将它们同时放在最容易感染霉菌的环境中进行“染菌挑战”。
挑战试验的最终结果显示,已开封的酱油长霉了,而未开封的酱油全部都没有长霉。因此,从实验结果我们可以验证这个说法:酱油出厂前不会自带霉菌。日常选购时,也建议大家选择大品牌正规厂家生产的酱油。
问
无防腐剂和低盐调味品更容易长霉?
是的。
我们陆续收到许多消费者反映,希望给家人挑选绿色健康的食品。市面上有许多无防腐剂、低盐酱油,那么如果选择了这些产品,消费者有什么需要注意的吗?其实,从使用存放方面,这类产品通常有更多的特殊要求,需要特别留意。
实验表明,无防腐剂、低盐酱油相对更容易长霉。
食品防腐剂等食品添加剂是食品保质保鲜的重要保障。如果消费者选择了无防腐剂、低盐类调味品,要更注意正确的保存方式,有条件的放冰箱保存。
问
只有酱油会长霉吗?
不对!纯粮酿造的调味品如果保存不当更容易长霉。
所谓纯粮酿造,就是以大豆、小麦等粮食为原料,经过发酵、酿造等工艺制成的调味品,纯粮酿造的调味品包括酱油、黄豆酱等,如果保存不当是十分容易长霉的。此外,还有蚝油等调味品,尤其是纯蚝肉熬煮的蚝油,因为特别“鲜”,也很容易长霉,需要特别留意。
背后原因是什么?原来,调味品中含有丰富的蛋白质、氨基酸、矿物质等营养成分,这些营养成分不仅可以为我们人体提供重要的所需营养,同时也是“贪吃鬼”霉菌的最爱。如果我们使用后忘记盖好盖子,霉菌就有机可乘了!
我们从市面上随机选购了不同品牌的酱油、蚝油、黄豆酱、番茄酱、料酒、食醋的若干产品,模拟“敞开盖子环境”进行染菌挑战,结果酱油、蚝油、黄豆酱、番茄酱无一例外都长霉了。
而食醋因为酸度较高,料酒因为含有较高浓度的酒精,它们的防腐能力较强,所以几乎看不到霉菌。虽然如此,我们也不能掉以轻心,食醋、料酒也需要注意正确保存,避光、避高温,放在阴凉、干燥、通风处保存,避免快速挥发或是发生变质。
问
家里调味品如何保存才能避免长霉?
最重要是盖紧瓶盖、封好袋口!
正确保存三步走
1、使用完及时擦干净瓶口、袋口。
2、盖紧瓶盖,封好袋口!别怀疑,没盖好,就长霉!
3、正规厂家生产的调味品,在标签处都会有明显的贮存条件标识,请按提示做好贮存。
例如,酱油、蚝油、发酵酱、食醋、料酒等调味品开封后,应保存在干燥、通风、阴凉的地方,避免阳光直射和高温环境。
酱油、蚝油、发酵酱每次用完,有条件的就放进冰箱保存。
特别需要注意的是,无防腐剂、低盐类调味品更容易长霉,也最好放进冰箱保存。
4001102288 欢迎批评指正
All Rights Reserved 新浪公司 版权所有
